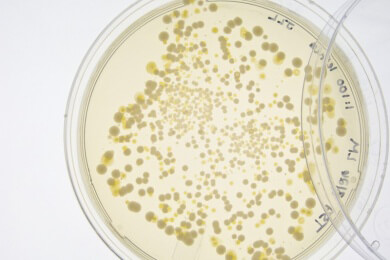
Mumienfund in Ungarn liefert neue Erkenntnisse über Tuberkulose

Infektionen News
Alle Kurzmeldungen zum Thema Infektionen.
Infektionskrankheiten werden durch spezielle Krankheitserreger wie Bakterien, Viren, Pilze, Parasiten oder Prionen hervorgerufen. Die Erreger werden übertragen indem sie über Verdauungstrakt, Haut, Schleimhäute oder Atemwege in den Körper eindringen.
2262 Kurzmeldungen zum Thema
- DIY-Masken: Mund-Nasen-Schutz sollte mindestens zweilagig sein
Da die Zahlen der Corona-Infizierten auch in Deutschland weiter hoch sind, bleibt es wichtig, ausreichend Abstand zu halten und einen ...
![DIY-Masken: Mund-Nasen-Schutz sollte mindestens zweilagig sein]()
- Viele schwere Infekte könnten auf Krebs hindeuten
Wer regelmäßig starke Infekte wie etwa eine saisonale Grippe hat, könnte an einer bislang nicht diagnostizierten Krebserkrankung leiden. Zu ...
![Viele schwere Infekte könnten auf Krebs hindeuten]()
- Hepatitis-Patienten könnten durch ASS ihr Risiko für Leberkrebs senken
In Schweden hat eine Studie untersucht, ob die regelmäßige Einnahme von Acetylsalicylsäure, unter dem Kürzel ASS bekannt, dazu beitragen ...
![Hepatitis-Patienten könnten durch ASS ihr Risiko für Leberkrebs senken]()
- Chlamydien im Hoden könnten Männer unfruchtbar machen
Zum ersten Mal ist es gelungen, im menschlichen Hoden die Bakterien der Familie Chlamydiaceae festzustellen. Sie werden umgangssprachlich auch ...
![Chlamydien im Hoden könnten Männer unfruchtbar machen]()
- HIV-Schutz für Frauen: Vaginalring schützt 30 Tage, Implantat eventuell 365 Tage
HIV-Präexpositionsprophylaxe ist ein sperriges Wort, doch es steht für den Versuch, Leben zu retten. Vor allem in vielen Regionen Afrikas, in ...
![HIV-Schutz für Frauen: Vaginalring schützt 30 Tage, Implantat eventuell 365 Tage]()
- Offenbar kein Ansteckungsrisiko bei HIV-infiziertem Partner in antiretroviraler Therapie
Wer den HI-Virus in sich trägt, ist bei ungeschütztem Sex ein großes Risiko für den Partner. Dieser kann sich ebenfalls infizieren, weshalb ...
![Offenbar kein Ansteckungsrisiko bei HIV-infiziertem Partner in antiretroviraler Therapie]()
- Der erste Wirkstoff gegen Epstein-Barr-Viren im Tierversuch erfolgreich
Das Epstein-Barr-Virus zählt zu den Herpes-Viren und besiedelt Schätzungen zufolge 90 Prozent der gesamten Menschheit. Bei der großen ...
![Der erste Wirkstoff gegen Epstein-Barr-Viren im Tierversuch erfolgreich]()
- Häufige Mandelentzündung im Kindesalter ist genetisch bedingt
Der Arzt spricht von einer Tonsillitis, wenn die Mandeln im Rachenraum entzündet sind. Gerade im Kindesalter haben viele Menschen damit zu ...
![Häufige Mandelentzündung im Kindesalter ist genetisch bedingt]()
- Klarinettenspielerin mit Kehlkopfkrebs: Vermutliche HPV-Infizierung von Mund zu Mund
Eine HPV-Infektion zählt zu den Geschlechtskrankheiten und kann zu Krebs führen. Der aktuelle Fall einer 18-Jährigen gab den Ärzten jedoch ...
![Klarinettenspielerin mit Kehlkopfkrebs: Vermutliche HPV-Infizierung von Mund zu Mund]()
- Neuer Impfstoff gegen Herpes zoster deutlich wirksamer
Wer sich einmal mit dem Windpocken-Virus infiziert hat, ist für den Rest des Lebens ein Träger dieses Erregers. Ist das Immunsystem ...
![Neuer Impfstoff gegen Herpes zoster deutlich wirksamer]()
- Neuer Impfstoff könnte erstmals vor Lassa-Fieber schützen
Sowohl die Tollwut als auch das Lassa-Fieber sind in westlichen Industrieländern kaum bekannt, doch in Westafrika sterben jährlich tausende ...
![Neuer Impfstoff könnte erstmals vor Lassa-Fieber schützen]()
- Neues Mittel Bedaquilin gegen Tuberkulose hilft auch bei multiresistenten Keimen
Die Tuberkulose ist in unserer Gegenwart die tödlichste Infektionskrankheit. Sie kostete laut Angaben der Weltgesundheitsorganisation WHO ...
![Neues Mittel Bedaquilin gegen Tuberkulose hilft auch bei multiresistenten Keimen]()
- Adipöse Grippepatienten sind länger ansteckend
Sind Menschen adipös, haben sie ein größeres Risiko für schwere Verläufe der Grippe. Diese Erkenntnis basiert auf Studien zu H1N1, der ...
![Adipöse Grippepatienten sind länger ansteckend]()
- Neuroborreliose nach Zeckenbiss: Lebenserwartung sinkt nicht
Ein Zeckenbiss kann weitreichende Folgen haben, wenn das betreffende Tier ein Träger der Bakterien Borrelia burgdorferi ist. Die Erreger ...
![Neuroborreliose nach Zeckenbiss: Lebenserwartung sinkt nicht]()
- Am Hepatitis-B-Virus starben Menschen bereits vor mehreren tausend Jahren
Der Hepatitis-B-Virus begleitet den Menschen offenbar schon viel länger als man denken mag. In unserer Gegenwart tragen ungefähr 257 Millionen ...
![Am Hepatitis-B-Virus starben Menschen bereits vor mehreren tausend Jahren]()
- Die Lepra im Mittelalter hat das europäische Genom nachhaltig verändert
Für die Europäer war sie im Mittelalter ein großes Problem: die Lepra. Die Bakterien infizierten und töteten im 13. und bis zum 15. ...
![Die Lepra im Mittelalter hat das europäische Genom nachhaltig verändert]()
- Forscher entwickeln kostengünstiges und wirksames Hepatitis-C-Heilmittel
Bislang ist die Behandlung von Hepatitis C schwierig. Um die Viren zu besiegen, muss eine kostenaufwendige Therapie gestartet werden. ...
![Forscher entwickeln kostengünstiges und wirksames Hepatitis-C-Heilmittel]()
- Das Bornavirus infiziert erstmals auch den Menschen
Das Bornavirus, benannt nach der Stadt Borna, wo es erstmals beschrieben wurde, war bislang als reine Tierkrankheit bekannt. Es befällt vor ...
![Das Bornavirus infiziert erstmals auch den Menschen]()
- Influenza mit Folgen: Die Grippe hinterlässt vorübergehend auch Schäden im Gehirn
Influenza-A-Viren führen beim Menschen zu einer schweren Grippe, samt Fieber und teils stationären Aufenthalten. Doch auch nach dem Abklingen ...
![Influenza mit Folgen: Die Grippe hinterlässt vorübergehend auch Schäden im Gehirn]()
- Studie zu HIV-Zahlen in Europa: Viele Diagnosen werden zu spät gestellt
Eine Infektion mit HIV kann heute so gut behandelt werden, dass ein Ausbruch von Aids verhindert wird und die Patienten eine nahezu normale ...
![Studie zu HIV-Zahlen in Europa: Viele Diagnosen werden zu spät gestellt]()
- Auslöser für die Durchfallerkrankung Campylobacter-Enteritis ist meist Hühnerfleisch
Bei dem Zungenbrecher Campylobacter-Enteritis handelt es sich um eine Infektion mit Bakterien, die in den Magen-Darm-Trakt wandern und dort das ...
![Auslöser für die Durchfallerkrankung Campylobacter-Enteritis ist meist Hühnerfleisch]()
- Der Hefepilz Candida auris tötet immer mehr Menschen - auch in Deutschland
Hefepilze sind in der Lebensmittelindustrie wichtig und besiedeln als harmlose Bewohner auch den menschlichen Körper. Doch genauso wie es bei ...
![Der Hefepilz Candida auris tötet immer mehr Menschen - auch in Deutschland]()
- Tripper im Rachenraum: Kann man die Geschlechtskrankheit mit normalen Mundspülungen bekämpfen?
Die umgangssprachlich als Tripper bezeichnete Gonorrhö zählt zu den häufigen Geschlechtskrankheiten. Betroffen sind vor allem Männer, die ...
![Tripper im Rachenraum: Kann man die Geschlechtskrankheit mit normalen Mundspülungen bekämpfen?]()
- Zusammensetzung der Vaginalflora beeinflusst HIV-Risiko
Ob ein HIV-positiver Mensch seinen Sexualpartner mit dem HI-Virus ansteckt, hängt von verschiedenen Faktoren ab. Bei Frauen ist es einer ...
![Zusammensetzung der Vaginalflora beeinflusst HIV-Risiko]()
- Infektionskrankheiten frühzeitig erkennen: Aasfliegen als Vorboten nutzen
Viele Infektionskrankheiten treten zunächst im Tierreich auf, bevor erste Fälle bei Menschen bekannt werden. Ebola beispielsweise stellte ...
![Infektionskrankheiten frühzeitig erkennen: Aasfliegen als Vorboten nutzen]()
- Infektionen treffen Männer oft stärker - Unterscheiden Erreger zwischen Männern und Frauen?
Bei klassischen Erkältungen wird oft mit einem Augenzwinkern gesagt, dass Männer mehr darunter leiden als Frauen. Allerdings gibt es ...
![Infektionen treffen Männer oft stärker - Unterscheiden Erreger zwischen Männern und Frauen?]()
- Trotz HIV-Infektion kein Aids? Es gibt Kinder mit natürlicher Aids-Resistenz
HIV ist eine Virusinfektion, die systematisch das Immunsystem schwächt. Über die Jahre kommt es daher zu immer mehr gesundheitlichen ...
![Trotz HIV-Infektion kein Aids? Es gibt Kinder mit natürlicher Aids-Resistenz]()
- Infektion mit dem Zikavirus im Mutterleib: Hirnschäden sind nicht immer sofort sichtbar
Der Zikavirus gilt besonders für Schwangere als sehr gefährlich, denn über die Plazenta kann auch das Ungeborene infiziert werden. Die ...
![Infektion mit dem Zikavirus im Mutterleib: Hirnschäden sind nicht immer sofort sichtbar]()
- Schwere Malaria abschwächen: Deutsche Forscher entwickeln eine Idee
Die Malaria wird durch Stechmücken übertragen. Der Parasit gelangt über das Blutsaugen in den Körper, wandert zur Leber und vermehrt sich ...
![Schwere Malaria abschwächen: Deutsche Forscher entwickeln eine Idee]()
- Erster Kontakt zu Grippeviren prägt das Immunsystem für den Rest des Lebens
Anders als bei einem grippalen Infekt ist die Infektion mit der "echten Grippe" (Influenza) eine sehr ernstzunehmende Erkrankung. Während ...
![Erster Kontakt zu Grippeviren prägt das Immunsystem für den Rest des Lebens]()
- Die Toxoplasmose kann offenbar das Gedächtnis beeinflussen
Der Parasit namens "Toxoplasma gondii" ist vor allem Katzenbesitzern ein Begriff. Der Erreger lebt im Darm von Katzen und kann über das ...
![Die Toxoplasmose kann offenbar das Gedächtnis beeinflussen]()
- Ansteckungsort Krankenbett: eingenistete Bakterien am besten durch UV-Licht-Desinfektion abtöten
Kliniken weltweit sind eine Brutstätte für Bakterien. Multiresistente Krankenhauskeime werden auch in westlichen Ländern immer mehr zum ...
![Ansteckungsort Krankenbett: eingenistete Bakterien am besten durch UV-Licht-Desinfektion abtöten]()
- HIV mit einer Pille täglich vorbeugen: EU lässt neue Prophylaxe zu
Weltweit kommt es jährlich zu circa 2,1 Millionen HIV-Infektionen. Allein 2015 starben 1,1 Millionen Infizierte an den Folgen. Um neben ...
![HIV mit einer Pille täglich vorbeugen: EU lässt neue Prophylaxe zu]()
- Ansteckung mit Zikaviren: Blutprodukte sind eine Gefahrenquelle
Das Zika-Virus breitet sich aus und sorgt für immer mehr Reisewarnungen. In tropischen Gebieten sind die Stechmücken weit verbreitet und ...
![Ansteckung mit Zikaviren: Blutprodukte sind eine Gefahrenquelle]()
- Der Dudelsack als Todesursache: Musiker infiziert sich mit Schimmelpilzen
Es klingt im ersten Moment wie ein makaberer Scherz, doch es handelt sich um einen wahren Fall der Medizin. In Großbritannien ist ein ...
![Der Dudelsack als Todesursache: Musiker infiziert sich mit Schimmelpilzen]()
- Syphilis auf dem Höchststand: Die Geschlechtskrankheit breitet sich in deutschen Großstädten aus
Bei vielen Krankheiten spielt der Entwicklungsstand einer Gesellschaft eine wichtige Rolle. Oft wüten Infektionen vor allem in ärmeren ...
![Syphilis auf dem Höchststand: Die Geschlechtskrankheit breitet sich in deutschen Großstädten aus]()
- Drei auf einen Streich? Neuer Wirkstoff bekämpft mehrere Tropenkrankheiten
Es gibt Infektionskrankheiten, die vor allem in den Tropen ein Problem sind. Die Umweltbedingungen vor Ort erleichtern es Parasiten, den ...
![Drei auf einen Streich? Neuer Wirkstoff bekämpft mehrere Tropenkrankheiten]()
- Wurminfektion und HIV: Durch Fadenwurm steigt die Ansteckungsgefahr
In tropischen Ländern sind viele Parasiten vertreten, die beispielsweise Stechmücken als Zwischenwirt wählen und beim Blutsaugen diese ...
![Wurminfektion und HIV: Durch Fadenwurm steigt die Ansteckungsgefahr]()
- Wie lange leben Erreger auf Plastik-Spielzeug? Die erschreckende Antwort: bis zu 24 Stunden
Es gibt kaum eine Kindertagesstätte, in der man nicht Spielzeug aus Plastik vorfindet. Auch viele öffentliche Plätze arbeiten mit montiertem ...
![Wie lange leben Erreger auf Plastik-Spielzeug? Die erschreckende Antwort: bis zu 24 Stunden]()
- In Russland verstirbt ein Kind an Milzbrand
Milzbrand wird in der Medizin auch Anthrax genannt und gilt in Russland als seltene Infektionskrankheit. Auch in Deutschland gab es seit über ...
![In Russland verstirbt ein Kind an Milzbrand]()
- Malaria durch Duftstoffe bekämpfen: Warum viele Stechmücken Hühner meiden
Malaria kann für den Menschen sehr gefährlich werden und ist in vielen Ländern weit verbreitet. Der Überträger ist ein häufiger Begleiter ...
![Malaria durch Duftstoffe bekämpfen: Warum viele Stechmücken Hühner meiden]()
- Der Kampf gegen Chlamydien: zwei Impfstoffe gegen die Geschlechtserkrankung in der Testphase
Wer sich mit Chlamydien infiziert hat, leidet an einer der häufigsten Geschlechtserkrankung. Die Ansteckung erfolgt durch den Partner, der die ...
![Der Kampf gegen Chlamydien: zwei Impfstoffe gegen die Geschlechtserkrankung in der Testphase]()
- Worst-case-Szenario: 93 Millionen Zika-Infektionen und zehntausende Missbildungen befürchtet
Das Zika-Virus grassiert derzeit in vielen Teilen Lateinamerikas und auf den Inseln der Karibik. Erstmals entdeckt wurde der Erreger 1947 in ...
![Worst-case-Szenario: 93 Millionen Zika-Infektionen und zehntausende Missbildungen befürchtet]()
- Zika-Virus übertragen: Frau infiziert beim Sex ihren Partner
Das Zika-Virus hat 2016 eine traurige Berühmtheit erlangt, als die Weltgesundheitsorganisation WHO einen weltweiten Notstand ausrufen musste. ...
![Zika-Virus übertragen: Frau infiziert beim Sex ihren Partner]()
- Tod nach der Rafting-Tour: Amöbe zerstört das Hirngewebe einer 18-Jährigen
Mit echtem Unglaube dürften viele US-Amerikaner in den Medien erfahren haben, wie eine 18-Jährige aus North Carolina verstorben ist. Das ...
![Tod nach der Rafting-Tour: Amöbe zerstört das Hirngewebe einer 18-Jährigen]()
- Medikamente gegen Malaria: Günstigere Gewinnung durch Tabak?
In vielen Regionen der Welt ist die Malaria eine häufige und gefürchtete Krankheit. Zwar gibt es inzwischen wirksame Medikamente, doch der ...
![Medikamente gegen Malaria: Günstigere Gewinnung durch Tabak?]()
- Malaria hinterlässt bei Kindern Hirnschäden
Malaria ist eine Krankheit, die durch Mücken übertragen wird. Beim Blutsaugen gelangt der Parasit aus dem Körper der Mücke in den ...
![Malaria hinterlässt bei Kindern Hirnschäden]()
- Infektionen bei Kindern: Wie lange sollten sie Kita oder Schule fernbleiben?
Kindertagesstätten und Schulen haben immer wieder mit gehäuften Krankheitsfällen zu kämpfen. Klassisch sind Ausbrüche ...
![Infektionen bei Kindern: Wie lange sollten sie Kita oder Schule fernbleiben?]()
- Ebola verursacht Spätfolgen im Gehirn
Seit vor rund zwei Jahren die Ebola-Epidemie die Menschen in Westafrika heimsuchte, sind circa 28.000 Krankheitsfälle erfasst worden. Viele ...
![Ebola verursacht Spätfolgen im Gehirn]()
- Schutz vor HIV: Antikörper schützen Affen für Monate vor dem Virus
Der HI-Virus kann bisher nicht komplett besiegt werden, wenn er einmal im menschlichen Körper angekommen ist. Forscher arbeiten daher weltweit ...
![Schutz vor HIV: Antikörper schützen Affen für Monate vor dem Virus]()
- Blaualge beugt dem Herpesvirus vor
Viele Menschen haben ihn und müssen bei Stress und schwächelndem Immunsystem mit den schmerzenden Bläschen am Mund leben: der Herpes ...
![Blaualge beugt dem Herpesvirus vor]()
- Infektionen während der Schwangerschaft können Gehirn des Kindes beeinflussen
Ein normaler Schnupfen in der Schwangerschaft ist nicht selten und kein Grund zur Sorge. Wichtig sind ausreichend Ruhe und möglichst der ...
![Infektionen während der Schwangerschaft können Gehirn des Kindes beeinflussen]()
- Toxoplasmose in der Schwangerschaft: Viele Frauen infizieren sich unerkannt
Bei Toxoplasma gondii handelt es sich um einen Parasiten, der mit Malaria verwandt ist. Dringt er in den menschlichen Körper ein, kann er sich ...
![Toxoplasmose in der Schwangerschaft: Viele Frauen infizieren sich unerkannt]()
- Deutsche Forscher entwickeln Verfahren, um Schimmelpilze in der Lunge zu finden
Auch wenn die Vorstellung alles andere als angenehm ist: Jeder Mensch atmet beständig Schimmelpilzsporen ein. Sie befinden sich in der Luft und ...
![Deutsche Forscher entwickeln Verfahren, um Schimmelpilze in der Lunge zu finden]()
- Hepatitis C - Besitzen Infizierte ein größeres Risiko für Parkinson?
Patienten mit Hepatitis C sind mit einem Virus infiziert. Dieser Hepatitis C-Virus ist seit 1989 bekannt und betrifft weltweit rund 150 ...
![Hepatitis C - Besitzen Infizierte ein größeres Risiko für Parkinson?]()
- Impfstoff gegen Denguefieber nun auch in Brasilien zugelassen
Das Denguefieber zählt zu den gefährlichen Tropenkrankheiten. Übertragen durch Stechmücken, ähnelt es in seinem Verlauf einer Grippe, kann ...
![Impfstoff gegen Denguefieber nun auch in Brasilien zugelassen]()
- Wiederkehrender Scheidenpilz: Erkrankungsrisiko sinkt durch Ernährungsumstellung
Scheidenpilz betrifft viele Frauen und hat selten etwas mit mangelnder Hygiene zu tun. Was man umgangssprachlich als Scheidenpilz bezeichnet, ...
![Wiederkehrender Scheidenpilz: Erkrankungsrisiko sinkt durch Ernährungsumstellung]()
- Furunkel sind mehr als Pickel: Ausdrücken kann gefährlich werden
Wer schon einmal einen Furunkel am Körper hatte, der weiß zu gut, dass die schmerzenden Eiteransammlungen viel mehr als ein normaler Pickel ...
![Furunkel sind mehr als Pickel: Ausdrücken kann gefährlich werden]()
- Neue Therapie gegen Krebs: im Labor veränderter Malaria-Erreger tötet Tumorzellen ab
Die Entdeckung ist eine kleine Sensation und geschah zufällig, als Ärzte nach einem Impfstoff gegen Malaria speziell für Schwangere suchten. ...
![Neue Therapie gegen Krebs: im Labor veränderter Malaria-Erreger tötet Tumorzellen ab]()
- Infektionsgefahr bei Ebola: Spermien bleiben über Monate ansteckend
Auch nach dem Abklingen der Symptome bleibt der Ebola-Virus noch einige Zeit im Körper der Patienten nachweisbar. Es gibt klare ...
![Infektionsgefahr bei Ebola: Spermien bleiben über Monate ansteckend]()
- Hilfe gegen das JC-Virus: Ärzte erforschen aktive und passive Immuntherapie
Vom sogenannten JC-Virus haben die meisten Menschen noch nie etwas gehört. Die Abkürzung JC entstand durch die Initialen des ersten Patienten, ...
![Hilfe gegen das JC-Virus: Ärzte erforschen aktive und passive Immuntherapie]()
- Neue Wirkstoffe gegen Hepatitis C wirken auch bei gleichzeitiger HIV-Infektion
Mittel gegen Hepatitis C sind bisher rar gesät. Der Durchbruch in der Behandlung wurde erst vor kurzer Zeit gefeiert und versprach zum ersten ...
![Neue Wirkstoffe gegen Hepatitis C wirken auch bei gleichzeitiger HIV-Infektion]()
- Ein Mikrobizid soll HIV im Sperma bekämpfen und so die Ansteckungsgefahr mindern
Wer den HI-Virus in sich trägt, sollte niemals ungeschützten Sex haben, da die Ansteckungsgefahr extrem groß ist. Dennoch gibt es viele ...
![Ein Mikrobizid soll HIV im Sperma bekämpfen und so die Ansteckungsgefahr mindern]()
- Hepatitis Delta: Behandlungsmöglichkeiten verbessern sich langsam
Während Hepatitis A, B und C den meisten Menschen zumindest vom Namen her bekannt sind, können die wenigsten etwas mit Hepatitis Delta ...
![Hepatitis Delta: Behandlungsmöglichkeiten verbessern sich langsam]()
- Erster Impfstoff gegen Ebola ist erfolgreich
Es ist eine Erfolgsmeldung für die Medizinwelt. Seit dem März 2015 wird in einer großen Feldstudie getestet, ob der Impfstoff "rVSV-EBOV" ...
![Erster Impfstoff gegen Ebola ist erfolgreich]()
- Der erste Impfstoff gegen Malaria hat eine Zulassung
Malaria wird durch Stechmücken übertragen und führt jährlich zu rund einer halben Million Todesopfer. Um die Bedrohung dieser ...
![Der erste Impfstoff gegen Malaria hat eine Zulassung]()
- Ungeahnte Wirkung: Ein Sodbrennen-Mittel hilft gegen Tuberkulose
Magenschützer gegen Sodbrennen sollen die überschüssige Magensäure beseitigen und so für Ruhe sorgen. Oft kommen dabei die sogenannten ...
![Ungeahnte Wirkung: Ein Sodbrennen-Mittel hilft gegen Tuberkulose]()
- Das Dengue-Virus bekämpfen: Neuer Antikörper könnte zum Impfstoff werden
Das Dengue-Fieber ist nicht so bekannt wie Malaria und doch handelt es sich dabei um eine gefährliche Infektionskrankheit. Der Dengue-Virus ...
![Das Dengue-Virus bekämpfen: Neuer Antikörper könnte zum Impfstoff werden]()
- Neue Idee für einen HIV-Impfstoff schützt 50 Prozent der Affen im Tierversuch
In den letzten Jahrzehnten wurde viel nach einem Impfstoff gegen HIV geforscht und immer wieder gab es Rückschläge. Viele Wissenschaftler ...
![Neue Idee für einen HIV-Impfstoff schützt 50 Prozent der Affen im Tierversuch]()
- Mit Antibiotika gegen Tuberkulose: Neue Genanalyse soll Resistenzen anzeigen
Tuberkulose ist noch immer eine große Gefahr für viele Menschen. Jedes Jahr gibt es neun Millionen Neudiagnosen und jährlich versterben 1,5 ...
![Mit Antibiotika gegen Tuberkulose: Neue Genanalyse soll Resistenzen anzeigen]()
- Gefahr von Influenzaviren besser einschätzen
Influenzaviren, also Viren, die eine Grippe auslösen, sorgen immer wieder für Probleme. Nach der Vogelgrippe 2009 hatten zuletzt der ...
![Gefahr von Influenzaviren besser einschätzen]()
- Warzen im Kindesalter: Sollte man die Warze entfernen lassen?
Eltern machen sich natürlich Sorgen, wenn am Körper des Kindes eine Warze sichtbar wird. Selten ist dieses Phänomen nicht, denn fünf bis ...
- Neu entdeckte Viren aus den Tropen lösen keine Fieberschübe aus
Viren können für den Menschen sehr gefährlich werden, wenn das Immunsystem sie nicht in Schach halten kann. Vermehren sie sich zu stark im ...
![Neu entdeckte Viren aus den Tropen lösen keine Fieberschübe aus]()
- Masernerkrankung macht anfällig für andere Krankheiten: Immunsystem noch lange geschwächt
Eine Masernerkrankung führt dazu, dass Betroffene noch längere Zeit anfälliger für andere Krankheiten sind. Hatten Mediziner früher ...
![Masernerkrankung macht anfällig für andere Krankheiten: Immunsystem noch lange geschwächt]()
- Peptid aus dem menschlichen Körper kann HIV blockieren
Die Bausteine eines Eiweiß nennt man in der Biologie Peptide. Von diesen gibt es Millionen von verschiedenen Arten, die bisher in ihrer ...
![Peptid aus dem menschlichen Körper kann HIV blockieren]()
- Die Gefahr für Thyphus: ein resistenter Erreger verbreitet sich weltweit
Thyphus gehört zu den gefürchteten Infektionskrankheiten und wird durch Bakterien übertragen. Durch den zu sorglosen Umgang mit Antibiotika ...
![Die Gefahr für Thyphus: ein resistenter Erreger verbreitet sich weltweit]()
- HIV geht auf die Augen: Infizierte erkranken häufiger an einer Makuladegeneration
Wer HI-Viren in sich trägt, kann bisher von der Infektion nicht geheilt werden. Es gibt jedoch Therapien, um HIV in Schach zu halten und damit ...
![HIV geht auf die Augen: Infizierte erkranken häufiger an einer Makuladegeneration]()
- Smartphone-Mikroskop findet Fadenwürmer im Blut
Rund zehn Millionen Menschen in Afrika leiden an einer Loa-loa-Infektion. Die Fadenwürmer befallen beim Menschen das Unterhautfettgewebe und ...
![Smartphone-Mikroskop findet Fadenwürmer im Blut]()
- Eiweißbaustein im Körper bremst HIV aus: Hoffnung auf neues AIDS-Medikament
Forscher der Universität Ulm sind einem Eiweißbaustein auf die Spur gekommen, das möglicherweise beim Kampf gegen AIDS eingesetzt werden ...
![Eiweißbaustein im Körper bremst HIV aus: Hoffnung auf neues AIDS-Medikament]()
- Neue Therapie bei schwerer Grippe: Blutgerinnungshemmer erfolgreich getestet
Jährlich kommt es weltweit zu bis zu 500.000 Todesfällen durch eine schwere Grippe, die u.a. mit Lungenentzündungen einhergeht. Forscher der ...
![Neue Therapie bei schwerer Grippe: Blutgerinnungshemmer erfolgreich getestet]()
- Chikungunya-Fieber auf dem Vormarsch: Erstmals Hoffnung auf Impfstoff
Das von Mücken übertragene Chikungunya-Fieber hat sich in den letzten Jahren stark ausgebreitet. Ursprünglich war der von der asiatischen ...
![Chikungunya-Fieber auf dem Vormarsch: Erstmals Hoffnung auf Impfstoff]()
- Gentherapie heilt Ebola im Tierversuch
Die Behandlung von Ebola gestaltet sich noch immer schwierig. Es gibt jedoch einen Wirkstoff in der Testphase, der zumindest bei Makaken bereits ...
![Gentherapie heilt Ebola im Tierversuch]()
- Hepatitis C: Neue Behandlung sehr effektiv aber auch sehr teuer
Hepatitis C ist eine Virusinfektion, die man keineswegs auf die leichte Schulter nehmen sollte. Jährlich sterben rund eine Million Patienten an ...
![Hepatitis C: Neue Behandlung sehr effektiv aber auch sehr teuer]()
- Das Epstein-Barr Virus löst das Pfeiffersche Drüsenfieber aus
Einer Statistik zufolge erkranken bis zu 30 Prozent aller Erstsemester an US-amerikanischen Universitäten am Pfeifferschen Drüsenfieber. Da ...
![Das Epstein-Barr Virus löst das Pfeiffersche Drüsenfieber aus]()
- Neuer Masernschutz: Inhalieren statt spritzen
Um Menschen gegen die Masern zu impfen, setzt man in der Medizin bislang auf Impfstoffe zum Spritzen. Ein kleiner Pieks und die Sache ist ...
![Neuer Masernschutz: Inhalieren statt spritzen]()
- Ungewöhnliche Mediziner in Afrika: Riesenhamsterratten erschnüffeln Tuberkulose
Im afrikanischen Mosambik sind Riesenhamsterratten seit einigen Jahren für außergewöhnliche Dienstleistungen verantwortlich: Nachdem die ...
![Ungewöhnliche Mediziner in Afrika: Riesenhamsterratten erschnüffeln Tuberkulose]()
- Neue Behandlungschancen für HIV-Kranke: Antikörper reduzieren HI-Viren im Blut
Schon lange ist eine Infektion mit HIV kein Todesurteil mehr für Betroffene, doch sie erfordert die regelmäßige Einnahme von Medikamenten um ...
![Neue Behandlungschancen für HIV-Kranke: Antikörper reduzieren HI-Viren im Blut]()
- Mumienfund in Ungarn liefert neue Erkenntnisse über Tuberkulose
Noch immer sterben jedes Jahr mehr als eine Million Menschen an Tuberkulose. Wie lange die Infektionskrankheit schon ihre Opfer fordert, zeigt ...
![Mumienfund in Ungarn liefert neue Erkenntnisse über Tuberkulose]()
- Ebola-Schutzimpfung zeigt erste Erfolge trotz Nebenwirkungen
Seit dem Ausbruch der Ebola-Epidemie in mehreren westafrikanischen Ländern forschen Mediziner aus aller Welt fieberhaft an einer wirksamen ...
![Ebola-Schutzimpfung zeigt erste Erfolge trotz Nebenwirkungen]()
- Tests mit Ebola-Impfstoff verliefen vielversprechend
Das Ebola-Virus hat in Westafrika bereits mehr als 10.000 Todesopfer gefordert. Doch nun gibt es Hoffnung auf einen Impfstoff gegen den ...
![Tests mit Ebola-Impfstoff verliefen vielversprechend]()
- Schnelltest für Tuberkulose in Afrika erkennt multiresistente Stämme nicht
Bei der Diagnose von Tuberkulose werden heute meist molekulardiagnostische Schnelltests wie der Xpert MTB/RIF-Test eingesetzt, der von der ...
![Schnelltest für Tuberkulose in Afrika erkennt multiresistente Stämme nicht]()
- Sind es Bakterien oder Viren? Neuer Schnelltest soll Klarheit bringen
Der menschliche Körper beherbergt beständig eine Vielzahl an Mikroorganismen. Viele sind nützlich, andere werden vom Immunsystem in Schach ...
![Sind es Bakterien oder Viren? Neuer Schnelltest soll Klarheit bringen]()
- Hepatitis E bekämpfen: Neuer Impfstoff bewährt sich
Der genaue Aufbau des Virus Hepatitis E ist seit 1990 bekannt. In den letzten Jahrzehnten haben Forscher weltweit daran gearbeitet, einen ...
![Hepatitis E bekämpfen: Neuer Impfstoff bewährt sich]()
- Forscher entschlüsseln das Erbgut des Hakenwurms
Der Hakenwurm wird in der Medizin als "Ancylostoma ceylanicum" bezeichnet und kann als Parasit im Menschen leben. Schätzungsweise 900 Millionen ...
![Forscher entschlüsseln das Erbgut des Hakenwurms]()
- Gestern verteufelt, heute wieder angesagt: Salz schützt vor Infektionen
Lange Zeit galt der hohe Salzkonsum als eine der Hauptursachen für die sich ausbreitenden Herzinfarkte und Schlaganfälle in der westlichen ...
![Gestern verteufelt, heute wieder angesagt: Salz schützt vor Infektionen]()
- Masern-Welle in Deutschland: Auch ungeborene Babys gefährdet
Schon ungeborene Kinder können sich mit den Masern anstecken, wenn die Mutter nicht geimpft ist. Darauf weisen Frauenärzte anlässlich der ...
![Masern-Welle in Deutschland: Auch ungeborene Babys gefährdet]()
- Ebola-Spätfolgen: Erblindung, Haarverlust und Depressionen
Die Patienten, die eine Ebola-Infektion überlebt haben, leiden nicht nur an einem sozialen Stigma, sondern haben mit diversen Spätfolgen zu ...
- Neue Wirkstoffe gegen Hepatitis C helfen Patienten, die zugleich HIV-positiv sind
Neue Wirkstoffe, die Patienten nach der Infektion mit Hepatitis C helfen sollen, können auch von HIV-Positiven eingenommen werden. Das zeigen ...
![Neue Wirkstoffe gegen Hepatitis C helfen Patienten, die zugleich HIV-positiv sind]()
- Windpockenvirus Varicella zoster kann im Erwachsenenalter zu Riesenzellarteriitis führen
Windpocken gehören eigentlich zu den klassischen Kinderkrankheiten, mit denen Erwachsene nur selten in Berührung kommen. Allerdings kann das ...
![Windpockenvirus Varicella zoster kann im Erwachsenenalter zu Riesenzellarteriitis führen]()
- Neue Gentherapie soll ersten Impfstoff gegen HIV möglich machen
Bisher gibt es noch keinen Wirkstoff, der einen Menschen langfristig vor HIV schützen kann. Der HI-Virus kann zwar inzwischen relativ gut in ...
![Neue Gentherapie soll ersten Impfstoff gegen HIV möglich machen]()